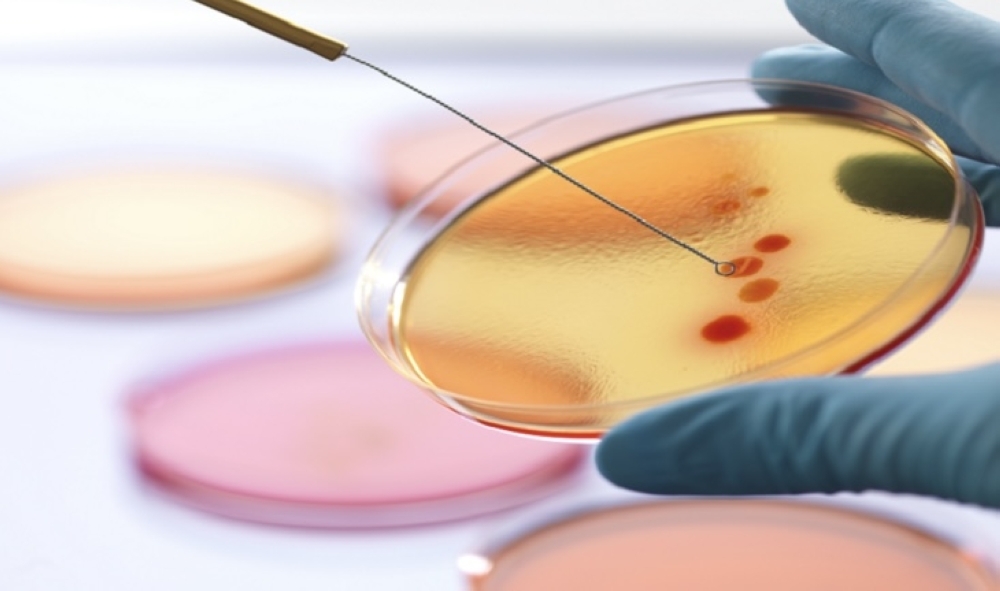

ووجد فريق دولي من الباحثين في جامعة ملبورن (معهد بيتر دوهرتي للعدوى والمناعة)، أن المضاد الحيوي المعروف باسم «ريفاكسيمين»، الذي يُستخدم غالباً لمرضى الكبد، يمكن أن يؤدي إلى ظهور سلالة مقاومة للمضادات الحيوية تُعرف بـenterococcus faecium المقاومة للفانكومايسين (VRE)، التي تسبب التهابات حادة غالبا ما تستدعي دخول المستشفى.
آثار سلبية
أكدت الدراسة أن استخدام «ريفاكسيمين» يسهم في مقاومة «دابتوميسين»، أحد آخر المضادات الحيوية الفعالة ضد عدوى VRE.
وتسلط الدراسة الضوء على أهمية فهم الآثار السلبية لاستخدام المضادات الحيوية، مما يعزز ضرورة الاستخدام المسؤول لهذه الأدوية في المجال الطبي.
واستندت الدراسة التي استمرت 8 سنوات، إلى مجالات متعددة، بما في ذلك علم الأحياء الدقيقة وعلم المعلومات الحيوية. وباستخدام تقنيات دراسة الجينوم، تمكن الباحثون من تحديد التغيرات في الحمض النووي للبكتيريا المقاومة لـ«دابتوميسين»، التي لم تكن موجودة في السلالات الحساسة.
نتائج الدراسة أظهرت التجارب المخبرية والدراسات السريرية أن استخدام «ريفاكسيمين» يؤدي إلى هذه التغيرات وظهور سلالات مقاومة.
وقال الدكتور غلين كارتر الباحث الرئيس في الدراسة، «لقد أثبتنا أن ’ريفاكسيمين’ يسهم في زيادة مقاومة البكتيريا لـ’دابتوميسين’ بطرق غير مسبوقة. وما يثير القلق هو إمكانية انتقال هذه البكتيريا المقاومة إلى مرضى آخرين في المستشفى، وهو ما نتحقق منه حاليا».
وأوضحت الدكتورة أدريانا تورنر، المعدة الرئيسية للدراسة، أن «ريفاكسيمين» يحفز تغييرات في إنزيم «بوليميراز الحمض النووي الريبي» داخل البكتيريا، مما يؤدي إلى زيادة تنظيم مجموعة جينات جديدة تؤثر على غشاء الخلية وتسهم في مقاومة «دابتوميسين».
تحذير مهم
أشار الأستاذ المساعد جيسون كوونغ طبيب الأمراض المعدية إلى نقطتين رئيسيتين: «يجب على الأطباء الحذر عند علاج عدوى VRE لدى المرضى الذين يتناولون ’ريفاكسيمين’ لأن فعالية ’دابتوميسين’ قد تتأثر».
كما أكد البروفيسور بنجامين هاودن، مدير مختبر الصحة العامة، أن هذه الدراسة ستسهم في ضمان استمرار فعالية «دابتوميسين» كعلاج لالتهابات VRE في المستشفيات، خاصة لدى المرضى الأكثر عرضة للخطر.
نُشرت الدراسة في مجلة Nature.